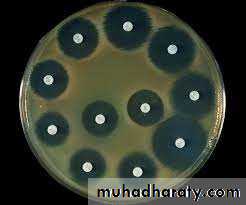
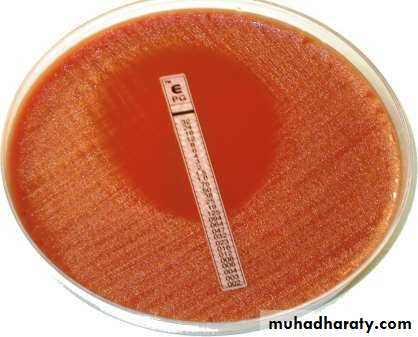
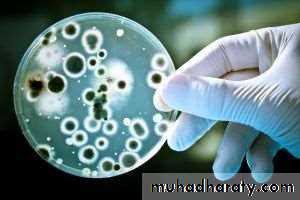

INVESTIGATIONS
Lecture 2Dr. Lana Shabur Talabani
• Based on where investigation is done:
• 7• Chair side Investigations
• Laboratory Investigations• Acts as a precursor to laboratory investigations
• Significantly higher sensitivity and specificity
• Egs : Toluidine blue staining for grading dysplasia, Electric Pulp testing for tooth vitality,
• Egs: Glycated Haemoglobin estimation,
• Peripheral smear histology
• Based on specificity/sensitivity:
• 8• Screening Tests
• Diagnostic Tests• An ideal screening test is 100% sensitive
• An ideal diagnostic test is 100% specific
• Useful in a large sample size at risk; typically cheaper
• Useful in symptomatic individuals to establish diagnosis or asymptomatic individuals with +ve screening test; expensive
• Egs : blood glucose estimation for screening diabetes,
• Haematocrit values for anaemia,
• VDRL test for syphilis
• Egs: Glycated Haemoglobin estimation, OGTT Peripheral smear histology
• 9
• Haematology• Histopathology
Biochemistry• Immunology
• Urinalysis• Biochemistry
• Cytopathology• 10
• Frequently used:
• CBC- Hb, Hct, Absolute and differential WBC• Bleeding studies – BT,CT, PT, aPTT
• Peripheral Blood Smear
• Random Blood Glucose
• Occasionally done:
• Tests for disturbance of bone – Ca, P, ALP• ESR
• Urinalysis
• Screening Test for Syphilis
• Rarely ordered:
• Enzyme testing• Bilirubin Estimation
• Creatinine Estimation
• Acid Phosphatase
• BUN
• COLLECTION OF BLOOD SAMPLE
• CAPILLARY BLOOD SPECIMENS: The specimen is obtained by pricking the patient`s finger .
• VENOUS BLOOD SPECIMEN: Most Commonly used method. Venipuncture is usually performed in ANTECUBITAL vein.• WBC count
• Differential Leukocyte count• RBC count
• Hemoglobin
• Hematocrit
• Erythrocytes indices
• Platelet Count
• Bleeding time
• Capillary Fragility Test
• Clotting Time
• erythrocyte Sedimentation Rate
• TYPES OF HEMATOLOGICAL INVESTIGATIONS
• Complete Blood Count
• COMPLETE BLOOD COUNT
• Complete blood count (CBC) is one of the most commonly ordered blood tests.
• The complete blood count is the calculation of the cellular (formed elements) of blood.• What are the components of the complete blood count (CBC)?
• The complete blood count, or CBC, lists a number of many important values. Typically, it includes the following:• White blood cell count (WBC or leukocyte count)
• WBC differential count• WBC
• Red blood cell count (RBC or erythrocyte count)
• Hematocrit (Hct)• Hemoglobin (Hbg)
• Mean corpuscular volume (MCV)
• Mean corpuscular hemoglobin (MCH)
• Mean corpuscular hemoglobin concentration (MCHC)
• RBC
• Platelet count• PLATELET
• White blood cell count (WBC) is the number of white blood cells in a volume of blood.
• Normal range of WBC= 4,500 - 10,000 cells/mm3 of blood.
• WBC/Leukocyte Count
• Specific causes of Leukocytosis:
• Infection- Acute and Chronic• Leukaemia
• Polycythemia
• Trauma
• Exercise , Stress and fear
• After general anesthesia
• Allergy
• Drugs, such as corticosteroids and epinephrine
• Rheumatoid arthritis
• Smoking
• Specific causes of Leukopenia:
• Aplastic anaemia• Influenza, measles and Respiratory tract infection
• Early Leukaemia
• Depression of Bone marrow
• Drug and chemical toxicity
• Shock
• Granulocytes
• Neutrophils• Eosinophils
• Basophils
• Agranulocytes
• Lymphocytes• Monocytes
• White blood cell (WBC) differential count:
• White blood cells are comprised of several different types of cells that are• differentiated, or distinguished, based on their size and shape.
• WBC
• Differential Count WBC
• Normal values:
• Granulocytes (or polymorphonuclears)• Neutrophils: 43-77% (3000-7000)
• Eosinophils: 0-4% (50-200)
• Basophils: 0-2% (0-100)
• Agranulocytes (or mononuclear)
• Lymphocytes: 17-47 %(1000-3500)
• Monocytes: 2-9%(100-600)
• CLINICAL SIGNIFICANCE
• DECREASES in:• Aplastic Anaemia Cyclic Neutropenia Malignant Neutropenia Early Leukemia
• Neutrophils INCREASES in: Inflammatory disease Stress
• Exercise Pregnancy Acute Infection Excitement
• Eosinophils INCEASES in: Parasitic infections Hypersensitivity/ Allergic responses Scarlet Fever
• DECREASES in:
• Immune defect Acute stress Typhoid Fever Aplastic Anaemia
• DECREASES in:
• Acute Infection• Severe injury
• Basophils INCREASES in: Chronic leaukemia Myelofibrosis Polycythemia
• DECREASES in:
• Aplastic Anaemia
• Lymphocytes INCEASES in: Lymphocytic Leukemia Mumps
• Whooping Cough
• Chronic Infection
• DECREASES in:
• Aplastic Anaemia• Monocytes INCREASES in:
• Monocytic leukemia Hodgkin disease Malaria – Kala -azar SABE
• TB
• Infectious mononucleosis
• Most common sign of neutropenia is ulceration of oral mucosa.
• Ulcers lack surrounding inflammation and are characterized by necrosis.• Advanced periodontal disease,paricoronitis, pulpal infections.
• Most common sign of leukemia- cervical lymphadenopathy
• Others-pallor of the mucosa, petechiae,echymosis, gingival bleeding, oral ulcers, oral infections(candidiasis)
• RBC Count
• cells in a volume of
• Red Blood cell count (RBC) signifies the number of red blood blood.• Normal range : 4.2 to 5.9 million cells/cmm.
• This can also be referred to as the Erythrocyte count• It can be expressed in international units:4.2 to 5.9 x 1012 cells
• per liter.
• An increase in red blood cell mass is known as Polycythemia.
• PV is a chronic myeloproliferative disease characterized by a predominant proliferation of the erythroid cell line.• Oral manifestations: purplish red discoloration of oral mucosa, gingivae and tongue,
• Gingivae are markedly swollen and bleed spontaneously but not ulcerated
• Petechiae are common
• Severe hemorrhage after dental extractions and periodontal surgery
• Smokers also have a higher number of red blood cells than non-smokers.
• INCREASE in RBC Count
• DECREASE in RBC Count
• Massive RBC loss, such as acute hemorrhage
• Abnormal destruction of red blood cells• Lack of substances needed for RBC production
• Chemotherapy or radiation side effects from treatment of bone marrow malignancies such as leukemia can result in bone marrow suppression.
• HEMOGLOBLIN
• Hemoglobin is the protein molecule within red blood cells that carries oxygen and gives blood its red color.
• Normal range =13-18 grams per dl for men and
• 12-16 grams per dl for women• A low haemoglobin count can also be due to blood loss
• Diseases and conditions that cause the body to destroy red blood cells faster than they can be made:
• Enlarged spleen (splenomegaly)
• Sickle cell anemia
• Thalassemia
• Vasculitis
• It is a measure of volume percent of packed red blood cells to that of whole blood.
• Normal results : Male: 40.7 - 50.3%• Female: 36.1 - 44.3%
• Hematocrit (Hct)
• Erthrocytes Indices
• To evaluate the nature of Anaemia, assistance is obtained by calculating standard indices relating to the size of RBCs.• By measuring these indices we can classify anaemia as Microcytic, Macrocytic And Normocytic and Hypochromic and Normochromic.
• Types
• MCH• MCHC
• MCV• The Haemoglobin content of erythrocyte is referred to as the Mean Corpuscular Haemoglobin(MCH) expressed in picogram of haemoglobin per cell.
• MCH = Haemoglobin concentration (g/dl) × 100 RBC in million/mm3
• Mean Corpuscular Haemoglobin (MCH)• The concentration of Haemoglobin in the erythrocyte is referred to as the Mean Corpuscular Haemoglobin Concentration.(MCHC) expressed in picogram of haemoglobin per cell.
• MCHC = Haemoglobin concentration (g/dl) × 100
• Hematocrit
• Mean Corpuscular Haemoglobin Concentration (MCHC)
• The average red cell volume is referred to as the Mean Corpuscular Volume(MCV) . It is expressed in cubic microns per cell.
• MCV = Hematocrit × 100 RBC in million /mm3
• Mean Corpuscular Volume (MCV)• PLATELET/THROMBOCYTE COUNT
• The number of platelets in a specified volume of blood. Platelets play a vital role in Haemostasis.
• Normal range (Adult) =150,000 to 400,000/ cmm of blood.
• (150 to 400 x 109/ L)• Normal range(Children) =150,000-450,000 /cmm of blood.
• (150-450 x 109/L)
• Interpretation of Platelet count
• THROMBOCYTOSIS:
• Post operative phase Pregnancy• Post partum phase Haemolytic Anemia Trauma Polycythemia vera
• Chronic myelocytic leukemia
• THROMBOCYTOPENIA:
• Acute leukemia• Idiopathic thrombocytopenic purpura Aplastic anemia
• Effect of chemotherapy Hypersplenism
• It is the measure of the rate at which RBCs sediments in a period of one hour.
• Also called as Sedimentation Rate or Westergren ESR• It is a non-specific measure of inflammation.
• Also helpful in following progress of some chronic infections (TB and Osteomylelitis)
• Normal ESR
• Male: 0-15 mm per hr• Female: 0- 20 mm per hr
• Erythrocyte Sedimentation Rate (ESR)
• Interpretation of ESR
• ESR increased: Tuberculosis Osteomyelitis Rheumatic fever Myocardial infarction Rheumatoid arthritis Hodgkin's disease Leukaemia
• ESR decreased: Congestive cardiac failure Polycythemia
• Severe dehydration like cholera• Physiologic condition where ESR is increased:
• Pregnancy: After intake of full meal
• It Measures the time required for hemostatic plug to form.
• Lack of any clotting factor or platelet abnormalities will prolong the bleeding time. It is used to screen disorders of platelet function and thrombocytopenia• Normal Bleeding Time: 2 - 6 minutes
• Methods are: Duke method (7-8 min)and Ivy’s method(5-6min)• Bleeding Time
• An abnormal Bleeding time- It is usually the result of abnormalities in the structure / abilities of capillaries to contract or abnormalities in the number (Thrombocytopenia) and functional integrity of platelets.• Interpretation of bleeding time
• Time required for coagulation to occur in a sample of whole blood outside the body is known as Clotting Time.
• Normal time- 3 to 7 minutes
• Method are:
• Capillary tube method
• Le and white’s test tube method
• Clotting Time
• An abnormal Clotting time- It is usually prolonged in diseases affecting stages of
• coagulation.• It is also increased in:Cirrhosis
• Hemophilia A and B• Factor XI deficiency, Hypofibringenemia and
• Heparin & Dicumarol therapy.
• Interpretation of Clotting time
• HEMATOLOGICAL INVESTIGATIONS
• (not so frequent in dentistry)• Prothrombin Time
• Partial Thromboplastin Time• INR
• It is the time in seconds that is required for development of a clot in citrated or oxalated plasma, where known amount of tissue thromboplastin and calcium is added.
• It is used to check the extrinsic pathway factor (F 7) and the common pathway ( F 5, 10 , prothrombin and fibrinogen).
• Normal range: 11 to 15 seconds
• Prolonged time (>3 times) indicates a hemorrhagic tendency.• It gets prolonged when plasma level of any factor is below 10% of its normal value
• PROTHROMBIN TIME
• Prothrombin Time (PT):
• Increased PT• Disseminated Intravascular Coagulation
• Patients on Warfarin Therapy
• Vit K deficiency
• Early & End stage Liver failure
• 56
• It is the time in seconds that is required for a clot to form in a sample of oxalated plasma, to which a partial thromboplastin reagent and calcium is added.
• It is used to check the intrinsic system (8, 9, 11, 12) and the common pathways (5, 10, prothrombin and fibrinogen).
• Normal range: 25-35 seconds
• If PTT is prolonged it indicates deficiency of factor 8 or 10• PARTIAL THROMBOPLASTIN TIME
• INR: INTERNATIONAL NORMALIZED RATIO• The International Normalised Ratio (INR) is a laboratory measurement of how long it takes blood to form a clot. It is used to determine the effects of oral anticoagulants on the clotting system.
• It is the ratio of Patient’s Prothrombin Time to that of normal Prothrombin time.
• INR= Patient`s PT• Normal PT
• It should be noted that INR is used to monitor Anti coagulant therapy & NOT be used as coagulation screening test
• INR values of 5.0 or greater indicate a serious risk of spontaneous bleeding episodes.
• NORMAL RANGE: 0.8-1.2 (No anticoagulant therapy)
• 02-03 (On anticoagulant therapy)
• Infiltration anesthesia , scaling and root planning
• INR <3• Block anesthesia , minor surgery , extraction
• INR <2• Major surgery
• INR <1.5• Serum Iron and Total Iron Binding Capacity:
• Iron deficiency is usually detected on the basis of the amount of iron bound to transferrin in the plasma(serum iron) and the total amount of iron that can be bound to the plasma transferrin in vitro.• Normal values
• Serum iron – 80-180 µg/dl
• TIBC – 250 – 370 µg/dl
• 60
• 61
• Glycated
• Haemoglobin(HbA1• c
• Fasting Plasma Glucose (FPG)
• Oral Glucose Tolerance
• Test (OGTT)
• Normal
• <5.7%
• <100 mg/dl
• <140mg/dl
• Prediabetes
• 5.7% to 6.4%
• 100 mg/dl to 125 mg/dl
• 140 mg/dl to 199 mg/dl
• Diabetes
• 6.5% or higher
• 126 mg/dl or higher
• 200 mg/dl or higher
• High values are seen in Diabetes mellitus, Cushing’s disease, pheochromocytoma, in patients taking corticosteroids
• Low values seen in insulin secreting tumours, Addison’s, Pituitary hypo function
• 63
• Oral Glucose Tolerance Test:
• Used for the definitive diagnosis of diabetes mellitus and for distinguishing diabetes from other causes of hyperglycaemia like hyperthyroidism• Should be performed on only healthy ambulatory patients who are not under any drugs which may interfere with glucose estimation
• 64
• Glycated Haemoglobin(HbA1c):
• The HbA1c fraction is abnormally elevated in diabetic patients with chronic hyperglycaemia• It is considered to be a better indicator for diabetic control compared to blood glucose levels.
• 65
• Mucosal conditions include oral dysesthesia, including burning mouth,
• Altered wound healing,• Increased incidence of infection,candidal infections (particularly acute pseudomembranous candidiasis of
• the tongue, buccal mucosa, and gingiva).
• Xerostomia and bilateral generalized salivary gland enlargement or sialadenitis (especially in the parotid glands) can occur and both are often related to poor glycemic control
• High incidence of dental caries.
• Dry mucosal surfaces
• Gingivitis and periodontitis
• Poor wound healing
• Serum Calcium,S Phosphorus:
• Indicated on suspicion of Paget’s disease, fibrous dysplasia, primary and secondary hyperparathyroidism, osteoporosis, multiple myeloma or osteosarcoma• The concn. of Serum Ca varies inversely with serum P
• Normal level Serum Ca – 9.2-11 mg/dl
• Normal level Serum P – 3- 4.5 mg/dl
• At levels less than 7 mg/dl Serum Ca, signs of tetany(n-m excitability,+ve chvostek’s
• sign) may appear.
• 67
• Serum Alkaline Phosphatase: (ALP)
• ALP produced in small amounts in the liver but most notably in osteoblasts• Normal values:
• 68
• ADULT
• CHILD• King Armstrong Units
• 3-13
• 15-30
• Bodansky Units
• 1-4
• 5-14
• International Units
• (IU/l)
• 30-110
• Serum Alkaline Phosphatase: (ALP)
• 69• High values
• Low values• Obstructive liver disease
• Hypophosphatasia
• Paget’s disease of bone hyperparathyroidism
• Hypothyroidism
• Osteomalacia
• Osteoporosis
• Rickets
• Aplastic/Pernicious anaemia
• Sarcoidosis
• Chronic Myeloid Leukaemia
• Lymphoma
• Wilson’s Disease
• Normal value:200-400U/L (LDH)
• For CPK male: 5-35 ug/ml (mcg/ml); female: 5-25 ug/ml• newborn: 10-300 IU/L
• Normal value:
• Total cholestrol :75-169 mg/dL for those age 20 and younger• 100-199 mg/dL for those over age 21
• HDL: >40 mg/dl
• LDL: <130 mg/dl
• TRIGLYCERIDES: <150 mg/dl
• Liver function tests(LFT) are helpful to detect the abnormalities and extent of liver damage.
• LFT assays are frequently more sensitive than clinical signs and symptoms.
• Typically the LFT comprises of:
• Total protein
• Albumin and globulin
• (Prothrombin Time)
• Transaminases – AST & ALT
• Alkaline PO4ase
• Bilirubin, usually fractionated
• Gamma Glutamyl Transpeptidase (GGT)
• Alanine Aminotransferase (ALT)/SGPT
• The test is primarily used to diagnose liver disease, to monitor the course of treatment for hepatitis, active post-necrotic cirrhosis, and the effect of drug therapy.• Normal value: 8-45 U/liter
• ALT is the most sensitive marker for liver cell damage.
• Aspartate Aminotransferase (AST)/SGOP:
• It may be elevated other conditions such as a myocardial infarct and muscle disease
• Normal value:<25 U/L
• .
• Gamma glutamyl transpeptidase:
• Normal value:9-48 U/L• Elevated levels of GGT : mainly alcoholic cirrhosis or individuals who are heavy drinkers
• Serum Bilirubin:
• Bilirubin is a bile pigment derived from the breakdown of Haemoglobin• Normal value: 0.1 – 1.2 mg/100ml
• Salivary function studies include:
• Measurement of Na, K, Cl concentration in saliva• Measurement of total salivary flow
• Rate of flow of saliva from orifices
• Rate of discharge of radio-opaque dye from salivary gland following retrograde sialography
• Rate of uptake and secretion of 99m Tc-pertechnate by salivary glands
• 85
• Normal values for unstimulated saliva are
• K – 25 mEq/L
• Na - <10 mEq/L
• Cl - 15-18 mEq/L
• Increase in K or Na values may indicate generic inflammation or sialodenosis
• In parotid enlargement accompanying cirrhosis
• Parotid flow rate and salivary concn of Na,K,Cl, salivary amylase & protein increases
• Immunoglobulin levels remain normal
• 86
• In Sjogren’s Syndrome
• Flow rate is reduced• Salivary phosphate concn is reduced
• Na & Cl concn is elevated
• Salivary IgA concn elevated
• Urea and K concn unchanged
• Abnormal protein bands can be distinguished by electrophoresis
• 87
• 89
• Culture and sensitivity tests are used to isolate and identify causative micro organisms of an infection
• May be obtained from blood or urine
• Particularly helpful in evaluating infections related to throat, sinuses, root canals or bone.
• Another problem is: in-vitro testing may not necessarily predict the same result as in-vivo testing
• 90
• 91
• This procedure employs the use of fluorescent labelled antibodies to detect specific Ag-Ab reaction of known specificity in tissue sections
• When tissue sections labelled in this fashion are illuminated with ultra violet light in an UV microscope, specific labelled tissue component can be identified by their bright apple green fluorescence against a dark background
• 92
• 93
• Histopathology refers to the microscopic examination of tissue in order to study the manifestations of the disease
• Cytopathology refers to the scientific study of role of individual cells or cell types in disease
• 98
• A biopsy is a controlled & deliberate removal of tissue from a living organism for the purpose of microscopic examination
• Relatively simple procedure producing little discomfort when compared to exodontia or periodontal surgery
• Indications:
• When signs and symptoms of an observed tissue change do not provide enough
• information to make a diagnosis
• When neoplasia is one of the differential diagnosis
• To confirm a clinical diagnosis
• 99
• Contraindications:
• The systemic health of the patient may contraindicate biopsy completely or at least cause its postponement• Site of the lesion may pose a risk to biopsy (for eg. Biopsy in richly vascularized areas may pose a risk of haemorrhage)
• Cases of clinically obvious malignant neoplasm should be referred directly to the appropriate specialist as biopsy would delay definitive care rather than accelerate it
• 100
• Avoidance of Delay for Biopsy:
• Rapid growth• Absent local factors
• Fixed lymph node enlargement
• Root resorption with loosening of teeth
• History of malignancy
• 101
• Uses:
• Diagnosis• Grading of tumours
• Metastatic lesions
• Recurrence
• Management Assessment
• 102
• Excisional
• biopsy:• Total excision of a small lesion for microscopic exam.
• Diagnostic + Therapeutic• Incisional Biopsy
• Performed by removing a wedge shaped specimen of pathological tissue along with surrounding normal zone• Punch Biopsy:
• With this technique the surgical defect produced is small and does not require suturing• Tissue is removed in same manner as incisional/excisional
• 103
• Advantages:
• Time saving• Painless
• Low cost
• No anaesthesia
• Screening test
• Rapid diagnosis
• Disadvantages:
• Firm tumours
• False negative results• Non assessment
• Indications:
• Patient preference• Debilitated patients
• Adjunct
• Rapid evaluation
• Population screening
• 106
• Microscopic examination of an aspirate obtained by inserting a fine needle into a lesion
• Painless and safe procedure for rapid diagnosis
• Indications:
• Salivary gland pathology
• As a replacement for extensive biopsy
• Cystic lesions
• Suspicious lymph nodes
• Recurrence
• Metastatic lesion
• 1
• 0
• 8